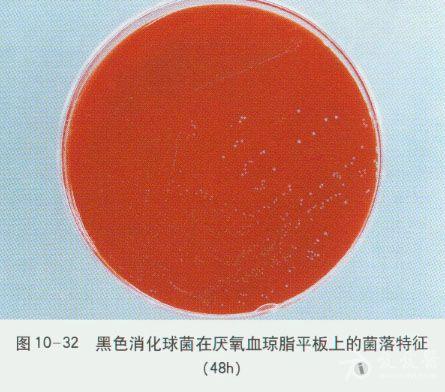
微生物图谱之厌氧菌

厌氧氨氧化菌

厌氧氨氧化菌词条图册_百度百科
图片尺寸690x370
深圳清泉水业_厌氧氨氧化工艺
图片尺寸445x295
红菌的厌氧氨氧化菌
图片尺寸260x240
这48页把厌氧氨氧化工艺说透了!
图片尺寸1080x810
厌氧氨氧化看来真不那么简单
图片尺寸456x339
求助厌氧氨氧化菌anammox菌怎样培养
图片尺寸675x900
厌氧氨氧化微生物活性测试gasendeavour
图片尺寸1280x1671
厌氧氨氧化菌的作用机理
图片尺寸1560x975
top研究010|苏州科技大学陈重军:厌氧氨氧化颗粒污泥的研究进展
图片尺寸412x608
红菌 厌氧氨氧化菌 1000毫升 支持发票
图片尺寸300x260
厌氧氨氧化菌颗粒污泥红菌脱氨氮实验室种泥anammox水处理
图片尺寸300x300
厌氧氨氧化微生物活性测试gasendeavour
图片尺寸1164x887
微生物图谱之厌氧菌
图片尺寸445x392
魏源送研究组在厌氧氨氧化技术处理猪场废水工程应用方面取得新进展
图片尺寸290x434
杭州河道治理厌氧氨氧化菌报价
图片尺寸640x320
【出售】厌氧氨氧化颗粒污泥 - 微生物 - 菌种资源 - 小木虫论坛-学术
图片尺寸800x599
山东造纸厌氧氨氧化菌去哪买真诚推荐山东浩妙生物工程供应
图片尺寸640x480
厌氧颗粒污泥,厌氧氨氧化颗粒污泥,颗粒污泥,活性污泥,红菌
图片尺寸1080x1440
缺氧及厌氧环境下厌氧氨氧化菌的衰减系数
图片尺寸3150x787
《自然》重磅 | 厌氧氨氧化菌可仅靠一氧化氮生长,氮循环教条再被改写
图片尺寸640x426